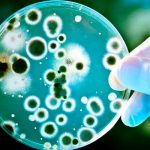
Bacterias del intestino podrían afectar la respuesta inmune al COVID salud

Etiqueta: intestino
Mujer de EE.UU. muere después de que un robot quirúrgico le quemara el intestino
Una tragedia ocurrió durante una cirugía en la que un robot quirúrgico, conocido como 'da Vinci', provocó un agujero en el intestino delgado de...
¿Cómo llegó ahí? Descubren una mariquita en el intestino de un hombre
De entre todas las cosas que el equipo de medicina esperaba encontrar en el colon de un paciente a través de una colonoscopia, jamás...
Bacterias del intestino podrían afectar la respuesta inmune al COVID
El estado del microbioma intestinal de una persona puede desempeñar un papel importante en la lucha del organismo contra la infección por coronavirus y...
Los prebióticos en tu dieta saludable desinflaman el intestino
Una dieta mediterránea, rica en prebióticos, con alimentos como la alcachofa, achicoria, cebolla, ajo, espárragos, cereales integrales y semillas, entre otras medidas, ayuda a...
Flora intestinal serviría para reducir inflamación de la esclerosis
Investigadores de la Universidad de Toronto y la Universidad de California en San Francisco descubrieron que el intestino es una fuente de células inmunitarias...
Un grupo de científicos descubrió una de las causas del autismo
En los últimos años, se han realizado diversas investigaciones que muestran la importancia del microbioma intestinal en nuestra salud: desde la respuesta al miedo...
¿Padeces de empacho? Estas son las maneras para aliviarlo
¿Sos de las personas que padeces de empacho? Pues aquí te contaremos todo sobre este mal y como se debe tratar.
El empacho, explica el...
Detectan una proteína «cazadora de azúcar» que alerta del cáncer
Un grupo de científicos de la Universidad de Copenhague (Dinamarca) ha relacionado el desarrollo de cáncer de colon con la presencia en los tejidos...
Mujer se quejaba de dolores y encuentran algo horrendo en su intestino
Una mujer de 41 años sufría de dolores en la zona abdominal por más de seis años, pero al no responder a la medicación...
Hongo intestinal puede ser útil como biomarcador de riesgo cardiovascular
Madrid, 11 dic (EFE).- El intestino humano puede albergar cien billones de microorganismos, sobre todo bacterias, pero también hongos aunque en menos proporción. La...